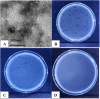

Isolation and characterization of a novel bacteriophage ST1749 and its effectiveness against Vibrio parahaemolyticus and Salmonella spp
- PMID: 40300702
- PMCID: PMC12123327
- DOI: 10.1016/j.virusres.2025.199579
Isolation and characterization of a novel bacteriophage ST1749 and its effectiveness against Vibrio parahaemolyticus and Salmonella spp
Abstract
Bacteriophages are extensively employed across various fields, including medicine, veterinary medicine, the food industry, agriculture, biotechnology, and pharmacy, owing to their numerous advantages. These advantages include rapid clearance of pathogens, self-propagation at the infection site, host specificity, potential for genetic modification, ease of isolation, stability, and low production costs. This study isolated a bacteriophage from shrimp pond wastewater in the Mekong Delta region. The bacteriophage was identified as a lytic bacteriophage belonging to the genus Bruyoghevirus, class Caudoviricetes, with the ability to effectively lyse three bacterial strains: V. parahaemolyticus, Salmonella enteritidis, and Salmonella typhimurium. Growth curve analysis revealed variations in the latency period and the number of phages produced during the life cycle across all three hosts. Bacteriophage Produced 117, 176, and 52 PFU/cell against V. parahaemolyticus, S. enteritidis, and S. typhimurium, respectively. Phage ST1749 demonstrated activity across a broad range of temperatures (-20 °C to 70 °C) and pH levels (2 to 10), with optimal stability observed at pH 5 to 7. Furthermore, phage ST1749 exhibited biofilm-degrading and lytic capabilities against the three bacterial strains studied. These findings suggest that phage ST1749 has the potential to serve as a biocontrol agent for treating infections caused by antibiotic-resistant bacteria.
Keywords: Bacteriophage st1749; Biocontrol; Biofilm; Bruyoghevirus; Caudoviricetes; Vibrio parahaemolyticus.
Copyright © 2025 The Authors. Published by Elsevier B.V. All rights reserved.
Conflict of interest statement
Declaration of competing interest The authors declare that they have no known competing financial interests or personal relationships that could have appeared to influence the work reported in this paper.
Figures

References
-
- Abd-El Wahab A., Basiouni S., El-Seedi H.R., Ahmed M.F.E., Bielke L.R., Hargis B., Tellez-Isaias G., Eisenreich W., Lehnherr H., Kittler S., Shehata A.A., Visscher C. An overview of the use of bacteriophages in the poultry industry: successes, challenges, and possibilities for overcoming breakdowns. Front. Microbiol. 2023;14 doi: 10.3389/fmicb.2023.1136638. - DOI - PMC - PubMed
-
- Abedon S.T. In: Bacteriophages: Biology, Technology, Therapy. Harper D.R., Abedon S.T., Burrowes B.H., McConville M.L., editors. Springer International Publishing; Cham: 2021. Detection of bacteriophages: phage plaques; pp. 507–538. - DOI
-
- Alves D.R., Gaudion A., Bean J.E., Perez Esteban P., Arnot T.C., Harper D.R., Kot W., Hansen L.H., Enright M.C., Jenkins A.T.A. Combined use of bacteriophage K and a novel bacteriophage to reduce Staphylococcus aureus biofilm formation. Appl. Environ. Microbiol. 2014;80:6694–6703. doi: 10.1128/AEM.01789-14. - DOI - PMC - PubMed
Publication types
MeSH terms
Substances
Associated data
- Actions
LinkOut - more resources
Full Text Sources
Miscellaneous